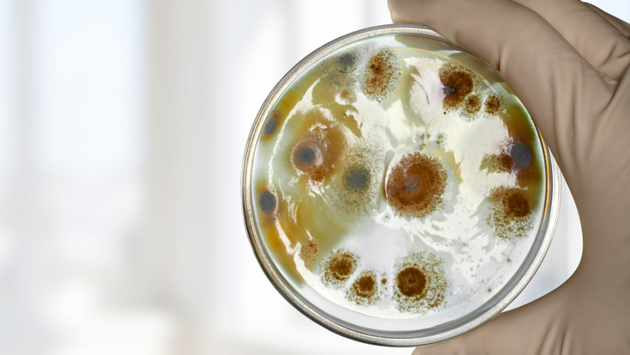

В России большинство детских онкологических центров находятся в плачевном состоянии. Об этом заявил главный детский онколог-гематолог Минздрава Александр Румянцев на пресс-конференции, посвященной Международному дню детей, больных раком. «70% детских онкологических отделений и больниц в регионах нуждаются в серьезном ремонте или полной реконструкции», — цитирует «Коммерсант» онколога. Он также отметил нехватку оборудования и неразвитость лабораторной диагностики. По словам Румянцева, условия в которых находятся онкобольные, существенно влияют на процесс выздоровления. Как сообщает издание, микробы, которые смогли выжить в больнице самые опасные. Согласно статистическим данным, более 30% смертей раковых больных случается именно из-за инфекций, так как такие люди обладают сниженным иммунитетом. Ранее российские врачи сообщили, что испытывают дефицит лекарств для лечения рака у детей. Уточняется, что в больницах есть аналоги зарубежных препаратов, но подходят они далеко не всем детям и помогают в лечении хуже.